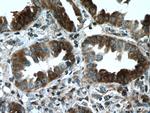
RABEPK/p40 Antibody in Immunohistochemistry (Paraffin) (IHC (P))

Search
Proteintech
RABEPK/p40 Polyclonal Antibody
{{$productOrderCtrl.translations['antibody.pdp.commerceCard.promotion.promotions']}}
{{$productOrderCtrl.translations['antibody.pdp.commerceCard.promotion.viewpromo']}}
{{$productOrderCtrl.translations['antibody.pdp.commerceCard.promotion.promocode']}}: {{promo.promoCode}} {{promo.promoTitle}} {{promo.promoDescription}}. {{$productOrderCtrl.translations['antibody.pdp.commerceCard.promotion.learnmore']}}
产品信息
15105-1-AP
种属反应
宿主/亚型
分类
类型
抗原
偶联物
形式
浓度
纯化类型
保存液
内含物
保存条件
运输条件
产品详细信息
Immunogen sequence: MKQLPVLEP GDKPRKATWY TLTVPGDSPC ARVGHSCSYL PPVGNAKRGK VFIVGGANPN GSFSDVHTMD LGKHQWDLDT CKGLLPRYEH ASFIPSCTPD RIWVFGGANQ SGNRNCLQVL NPETRTWTTP EVTSPPPSPR TFHTSSAAIG NQLYVFGGGE RGAQPVQDTK LHVFDANTLT WSQPETLGNP PSPRHGHVMV AAGTKLFIHG GLAGDRFYDD LHCIDISDMK WQKLNPTGAA PAGCAAHSAV AMGKHVYIFG GMTPAGALDT MYQYHTEEQH WTLLKFDTLL PPGRLDHSMC IIPWPVTCAS EKEDSNSLTL NHEAEKEDSA DKVMSHSGDS HEESQTATLL CLVFGGMNTE GEIYDDCIVT VVD (1-372 aa encoded by BC065725)
靶标信息
The protein encoded by this gene is a cytokine that acts as a regulator of a variety of hematopoietic cells. This cytokine stimulates cell proliferation and prevents apoptosis. It functions through the interleukin 9 receptor (IL9R), which activates different signal transducer and activator (STAT) proteins and thus connects this cytokine to various biological processes. The gene encoding this cytokine has been identified as a candidate gene for asthma. Genetic studies on a mouse model of asthma demonstrated that this cytokine is a determining factor in the pathogenesis of bronchial hyperresponsiveness.
仅用于科研。不用于诊断过程。未经明确授权不得转售。
篇参考文献 (0)
生物信息学
蛋白别名: 40 kDa Rab9 effector protein; p40; Rab9 effector p40; Rab9 effector protein with kelch motifs
基因别名: bA65N13.1; p40; RAB9P40; RABEPK
UniProt ID: (Human) Q7Z6M1
Entrez Gene ID: (Human) 10244